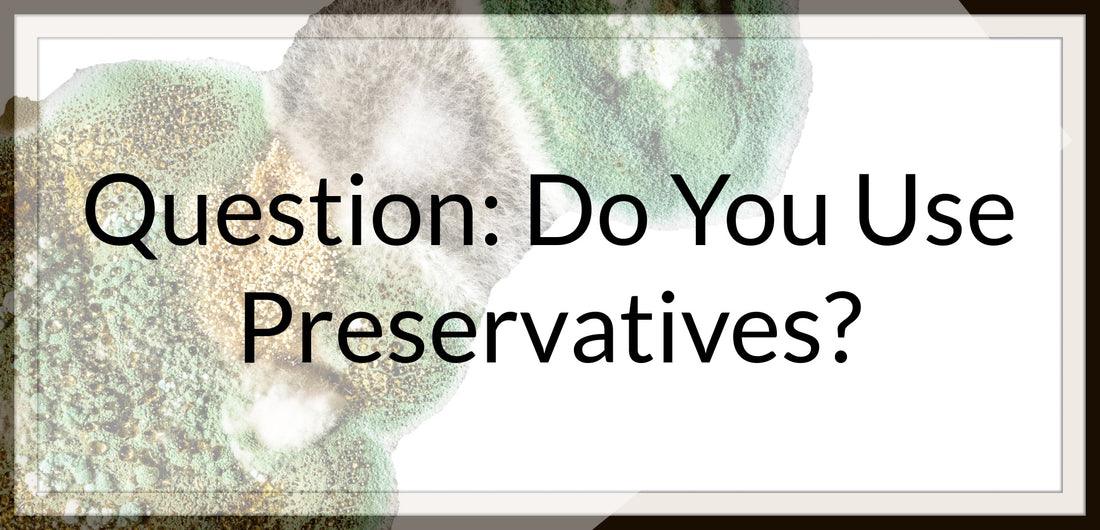
Question: Do You Use Preservatives?

Question: Do You Use Preservatives?
Share
First, lets clear the air about the word NATURAL. Natural will mean something different for each person. For some, natural means free from preservatives. For the product I handmake, natural means using naturally-derived ingredients to bring you clean, safe product.
Safe Product. This is the key phrase!
Second, as a rule, I follow the clean beauty standards created by Whole Foods. I use the standards set as a guide and reference which allows me to do further research into the raw ingredients I purchase. With using products like hydrosols and botanical extracts in my formulations, I'm already ahead of the game.
Now back to preservatives.
Yes, I use preservatives in all of my products that have a water base (i.e. cleansing water, toners) or could potentially come into contact with water (i.e. body scrubs).
The preservative that I currently use is officially called Euxyl® PE 9010 which is a combination of phenoxyethanol and ethylhexylglycerin.
This preservative is:
- A broad spectrum preservative
- Effective against both Gram-positive and Gram-negative bacteria
- Effective against yeast and mold
- Paraben free
- Formaldehyde free
In addition, we use the smallest amount recommended to get the job done. This means to be effective it is recommended between 0.5% to 1% of the total formula. For the majority of my products, I formulate with 0.60% to 0.85% as this is more than effective through stability testing.
With that said, yes, I'm in the testing phase of utilizing some additional naturally-derived preservatives made from such ingredients as, fermented radish, fermented coconut, and other probiotic options. But, as I continue testing, I will use a safe preservative for both you and the product you purchase.
To close out this post, please note that Vitamin E, Rosemary Extract, and Grapefruit Extract (or other similar) are NOT preservatives. While Vitamin E is certainly in my oil-based products - face oil, body oil, etc., - it only helps oils and butters remain more shelf-stable giving the product more time before going rancid it does not keep bacteria, yeast, and mold from growing in water based products.
I will update this post as preservatives change due to testing.
Updated: 08.23.23
Have a beautiful day!